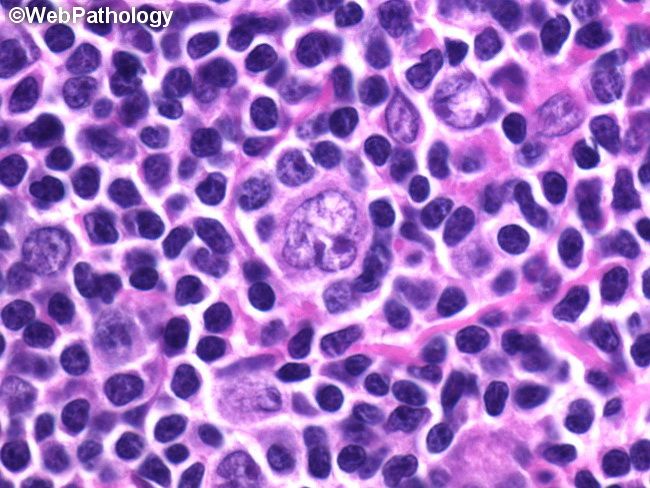

Смешанно клеточный вариант
Что значит ине
Внутренняя граната с приводом
Рецепты маринования для горячего копчения
Повторная прививка от кори взрослому
Годовые осадки бразилии
Зиртек таблетки прием
Всош по русскому языку 6 класс 2023
Что было в тайной комнате
Юлдашева национальность
Мотолэнд рязань
Makita bl1860b lxt 18в
Союз пародий красная плесень 828
Банд одесса каком
Смешанно клеточный вариант 117 фото